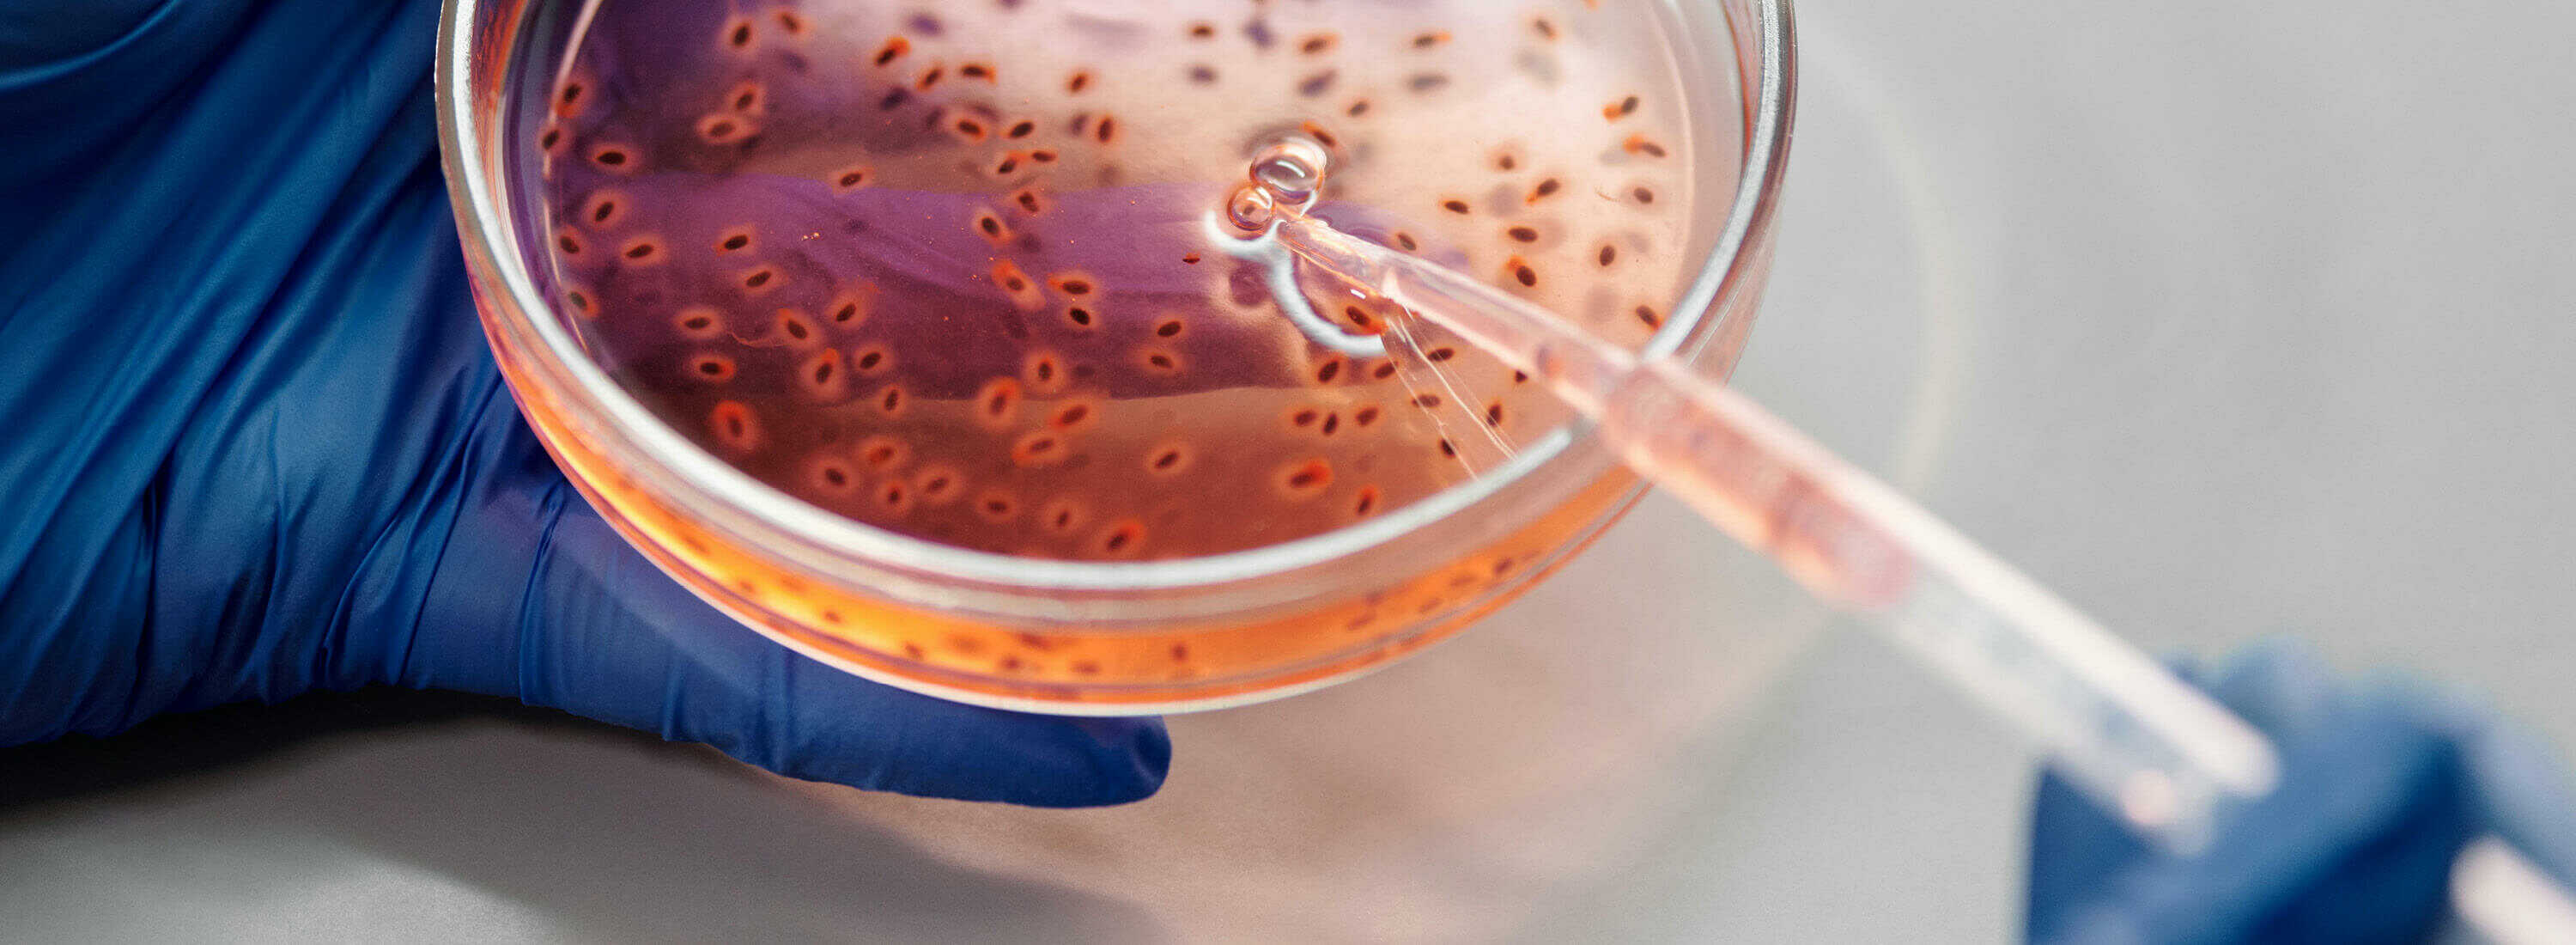
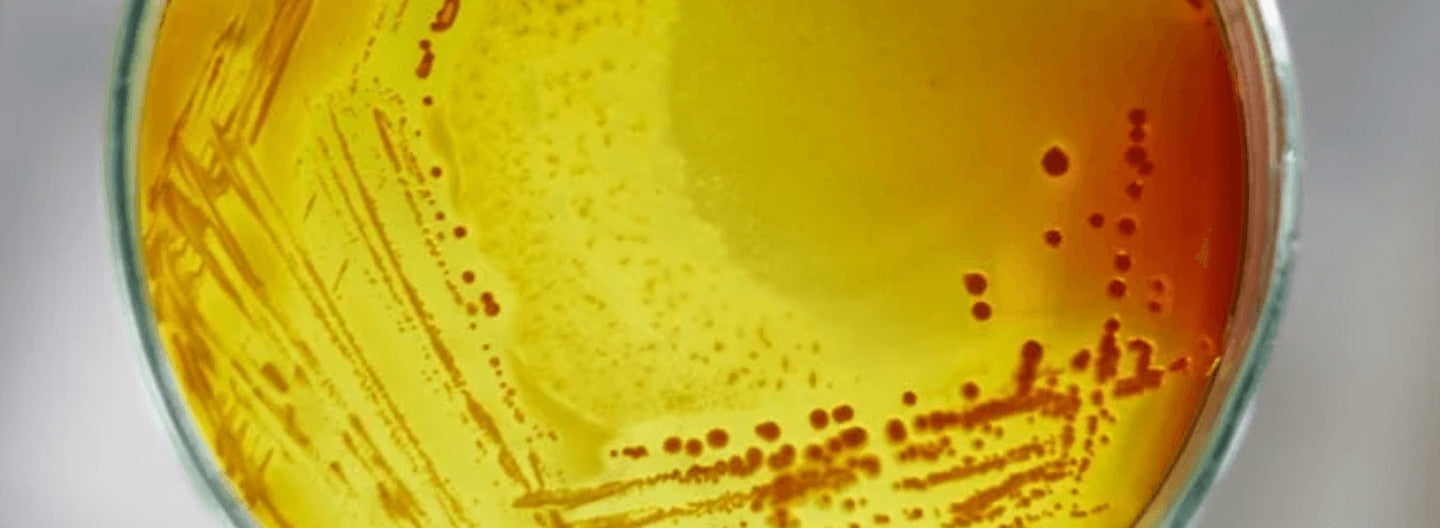

recipes
Probiotics, prebiotics & symbiotics: what are the differences?

Weight loss through probiotics and synbiotics: What does research say?

Tips for Strengthening Your Children's Immune System

Neurodermatitis in children: Can probiotics help?

Everything about Neurodermatitis: From Causes and Symptoms to Effective Treatment Methods

What you should know about rosacea

Decoding Acne: What You Should Know About This Skin Disease

Bacteria In Focus: From Spore Formation to Our Selection Criteria

Initial Worsening When Taking Probiotics: What You Should Know